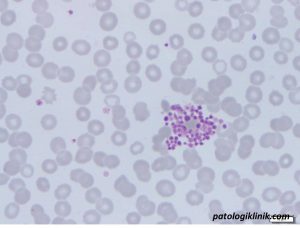
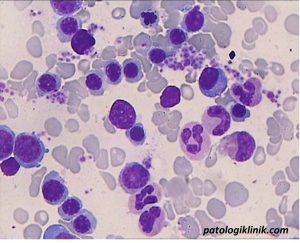

Cara Mengatasi Trombositopenia Palsu (Pseudotrombositopenia)
Pseudotrombositopenia atau trombositopenia palsu merupakan salah satu masalah laboratorium yang tidak jarang dijumpai, sekitar 0,1% dari populasi. Disebut pseudotrombositopenia karena sebenarnya jumlah trombosit pasien normal atau tidak serendah yang dilaporkan. Pseudotrombositopenia seringkali disebabkan oleh penggunaan antikoagulan EDTA (vakutainer ungu), karena adanya antibodi antitrombosit yang diinduksi oleh EDTA mengenali reseptor gpIIb-IIIa, merangsang ekspresi antigen aktivasi, memicu aktivasi tirosin kinase, aglutinasi dan clumping trombosit secara in vitro.
Kejadian pseudotrombositopenia ini perlu segera diidentifikasi, karena dengan adanya hasil trombosit yang rendah bisa menyebabkan kesalahan diagnosis, menghambat prosedur invasif yang sebelumnya telah direncanakan, atau pemberian transfusi TC yang tidak perlu. Ada 5 kriteria yang bisa dicurigai hasil trombosit tersebut merupakan pseudotrombositopenia:
- Trombosit rendah <100.000/ul
- Trombositopenia terjadi pada sampel dengan EDTA di suhu ruang
- Trombosit makin rendah sampai 4 jam setelah pengambilan sampel
- Terdapat agregat dan clumping trombosit pada apusan darah
- Tidak ada manifestasi klinis trombositopenia (mimisan, ptekiae, purpura, atau perdarahan yang lain)

Terdapat beberapa alternatif cara untuk mengatasi terjadinya pseudotrombositopenia pada suatu sampel, yaitu:
- Menghangatkan sampel pada suhu 37oC
- Menggunakan antikoagulan lain, yang paling sering digunakan adalah sodium sitrat (vakutainer biru muda)
- Menambahkan antibiotik, seperti amikacin pada sampel
- Melakukan vortex selama 30 detik
- Menghitung langsung menggunakan kamar hitung dengan penambahan amonium oksalat
- Menambahkan obat antiplatelet
Dari beberapa alternatif di atas, yang paling sering digunakan adalah penggunaan sodium sitrat sebagai pengganti EDTA. Perlu diingat bahwa jika menggunakan sodium sitrat, maka hasil hitung trombosit yang dikeluarkan oleh alat harus dikalikan 1,1. Jika laboratorium kita memiliki water bath, maka bisa dicoba menghangatkan sampel pada suhu 37oC dan dilakukan pemeriksaan ulang.
Semoga bermanfaat.
Referensi:
Lippi G and Plebani M. EDTA-dependent pseudothrombocytopenia: further insights and recommendations for prevention of a clinically threatening artifact. Clin Chem Lab Med 2012;50(8):1281–1285